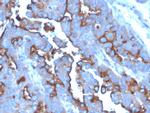
CD71/Transferrin Receptor (TFRC) Antibody in Immunohistochemistry (Paraffin) (IHC (P))

Search
NeoBiotechnologies
CD71/Transferrin Receptor (TFRC) Monoclonal Antibody (TFRC, 3630)
{{$productOrderCtrl.translations['antibody.pdp.commerceCard.promotion.promotions']}}
{{$productOrderCtrl.translations['antibody.pdp.commerceCard.promotion.viewpromo']}}
{{$productOrderCtrl.translations['antibody.pdp.commerceCard.promotion.promocode']}}: {{promo.promoCode}} {{promo.promoTitle}} {{promo.promoDescription}}. {{$productOrderCtrl.translations['antibody.pdp.commerceCard.promotion.learnmore']}}
产品信息
7037-MSM12-P1
种属反应
宿主/亚型
分类
类型
克隆号
抗原
偶联物
形式
浓度
规格
纯化类型
保存液
内含物
保存条件
运输条件
产品详细信息
Immunohistochemistry (PFA fixed): incubate antibody for 30 min RT. Staining of formalin-fixed tissues requires heating tissue sections in 10mM Tris with 1mM EDTA, pH 9.0, for 45 min at 95 degrees C followed by cooling at RT for 20 minutes.
靶标信息
Cellular uptake of iron occurs via receptor-mediated endocytosis of ligand-occupied transferrin receptor into specialized endosomes. Endosomal acidification leads to iron release. The apotransferrin-receptor complex is then recycled to the cell surface with a return to neutral pH and the concomitant loss of affinity of apotransferrin for its receptor. Transferrin receptor is necessary for development of erythrocytes and the nervous system. Serum transferrin receptor (sTfR) is used as a means of detecting erythropoietin (EPO) misuse by athletes and as a diagnostic test for anemias resulting from a number of conditions including rheumatoid arthritis, pregnancy, irritable bowel syndrome and in HIV patients.
仅用于科研。不用于诊断过程。未经明确授权不得转售。
篇参考文献 (0)
生物信息学
蛋白别名: CD antigen CD71; CD71; p90; T9; TR; transferrin receptor; Transferrin receptor 1; Transferrin receptor protein 1; unnamed protein product
基因别名: CD71; IMD46; p90; T9; TFR; TFR1; TFRC; TR; TRFR
UniProt ID: (Human) Q1HE24
Entrez Gene ID: (Human) 7037